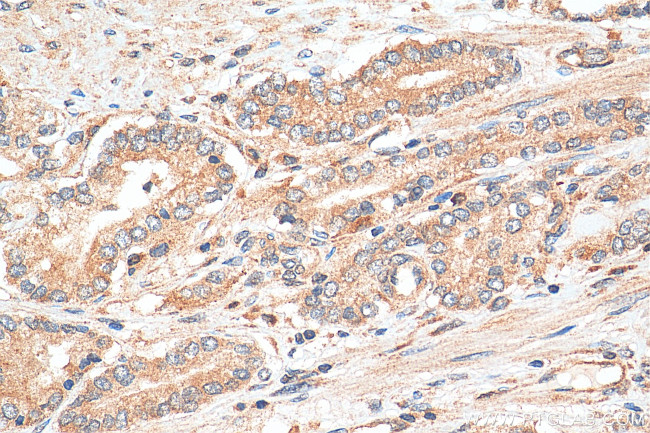
DHX36 Antibody in Immunohistochemistry (Paraffin) (IHC (P))

Search
Proteintech
DHX36 Polyclonal Antibody
{{$productOrderCtrl.translations['antibody.pdp.commerceCard.promotion.promotions']}}
{{$productOrderCtrl.translations['antibody.pdp.commerceCard.promotion.viewpromo']}}
{{$productOrderCtrl.translations['antibody.pdp.commerceCard.promotion.promocode']}}: {{promo.promoCode}} {{promo.promoTitle}} {{promo.promoDescription}}. {{$productOrderCtrl.translations['antibody.pdp.commerceCard.promotion.learnmore']}}
产品信息
13159-1-AP
种属反应
已发表种属
宿主/亚型
分类
类型
抗原
偶联物
形式
浓度
规格
纯化类型
保存液
内含物
保存条件
运输条件
产品详细信息
Immunogen sequence: MSYDYHQNW GRDGGPRSSG GGYGGGPAGG HGGNRGSGGG GGGGGGGRGG RGRHPGHLKG REIGMWYAKK QGQKNKEAER QERAVVHMDE RREEQIVQLL NSVQAKNDKE SEAQISWFAP EDHGYGTEVS TKNTPCSENK LDIQEKKLIN QEKKMFRIRN RSYIDRDSEY LLQENEPDGT LDQKLLEDLQ KKKNDLRYIE MQHFREKLPS YGMQKELVNL IDNHQVTVIS GETGCGKTTQ VTQFILDNYI ERGKGSACRI VCTQPRRISA ISVAERVAAE RAESCGSGNS TGYQIRLQSR LPRKQGSILY CTTGIILQWL QSDPYLSSVS HIVLDEIHER NLQSDVLMTV VKDLLNFRSD LKVILMSATL NAEKFSEYFG NCPMIH (1-385 aa encoded by B C036035)
靶标信息
DEAD box proteins, characterized by the conserved motif Asp-Glu-Ala-Asp, are putative RNA helicases implicated in several cellular processes involving modifications of RNA secondary structure. DHX36 (DEAH box protein 36), also known as MLE-like protein 1 and RNA helicase associated with AU-rich element ARE (RHAU), belongs to RNA helicase of the DEAH family and may function in sex development and spermatogenesis. It is expressed in testis and is evolutionary conserved with true orthologs in almost all animal species. DHX36 plays a role in degradation and deadenylation of mRNAs containing in their 3'-UTR the consensus ARE sequence element. DHX36 is required for early embryogenesis.
仅用于科研。不用于诊断过程。未经明确授权不得转售。
生物信息学
蛋白别名: Asp-Glu-Ala-His; ATP-dependent DNA/RNA helicase DHX36; ATP-dependent RNA helicase DHX36; DEAD/H (Asp-Glu-Ala-Asp/His) box polypeptide 36; DEAD/H box polypeptide 36; DEAH (Asp-Glu-Ala-His) box polypeptide 36; DEAH box protein 36; DEAH-box protein 36; G4 resolvase-1; G4-resolvase-1; G4R1; MLE-like protein 1; probable ATP-dependent RNA helicase DHX36; RNA helicase associated with AU-rich element ARE; RNA helicase associated with AU-rich element protein; unnamed protein product
基因别名: 2810407E23Rik; AI452301; AU022184; DDX36; DHX36; G4R1; KIAA1488; mKIAA1488; MLEL1; RHAU
UniProt ID: (Human) Q9H2U1, (Rat) D4A2Z8, (Mouse) Q8VHK9
Entrez Gene ID: (Human) 170506, (Rat) 310461, (Mouse) 72162